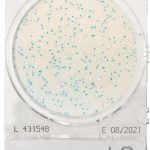

O Compact Dry é um método de ensaio microbiológico simples, seguro e específico, que permite determinar e quantificar microrganismos de alimentos, matérias-primas e ambientais. Possui uma fácil absorção das amostras inoculadas.
Balão Erlenmeyer em vidro, boca estreita, 1000 ml
Preço sob consulta
CompactDry SL (Salmonella), cx 40 placas
84,75€ sem IVA
CompactDry LS (Listeria), cx 40 placas
101,69€ sem IVA
Marca: CompactDry
Disponível por encomenda a fornecedor
REF:
1000899
Categorias: Em placa, Meios de Cultura
Descrição